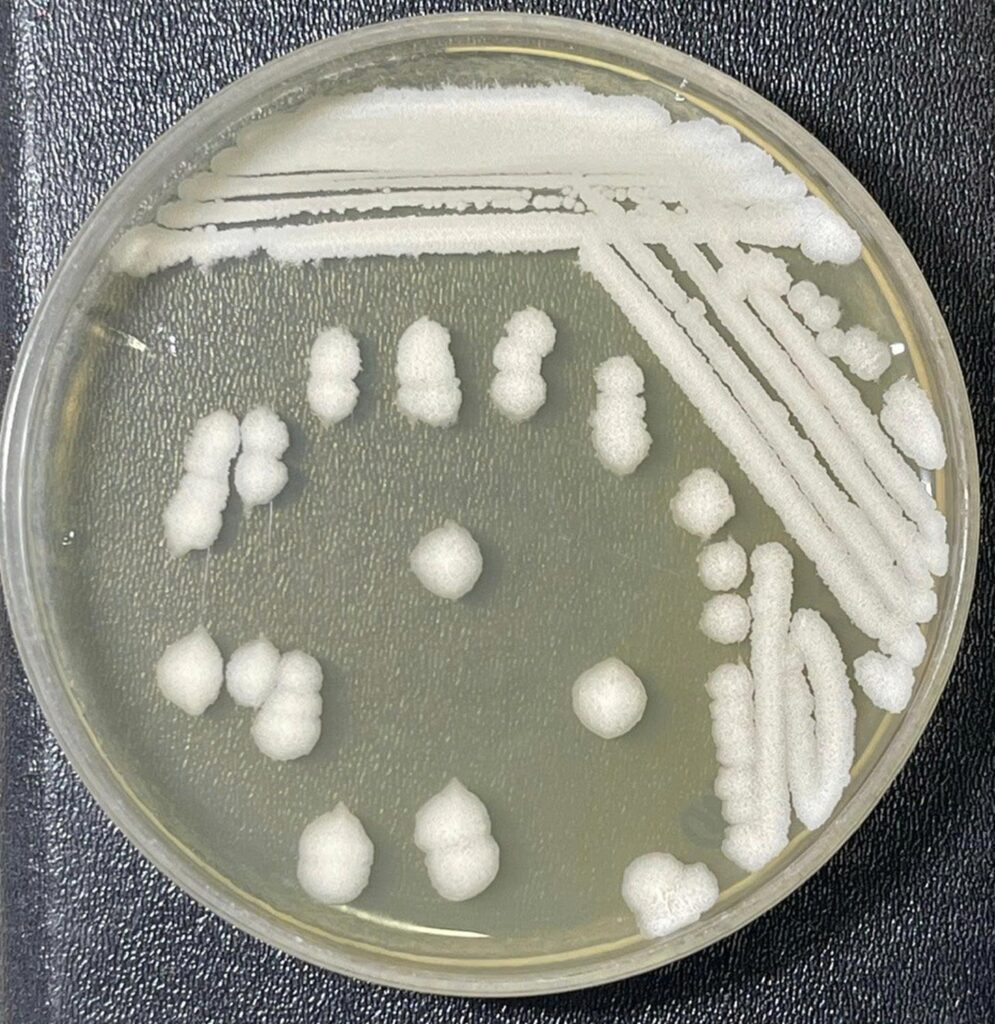
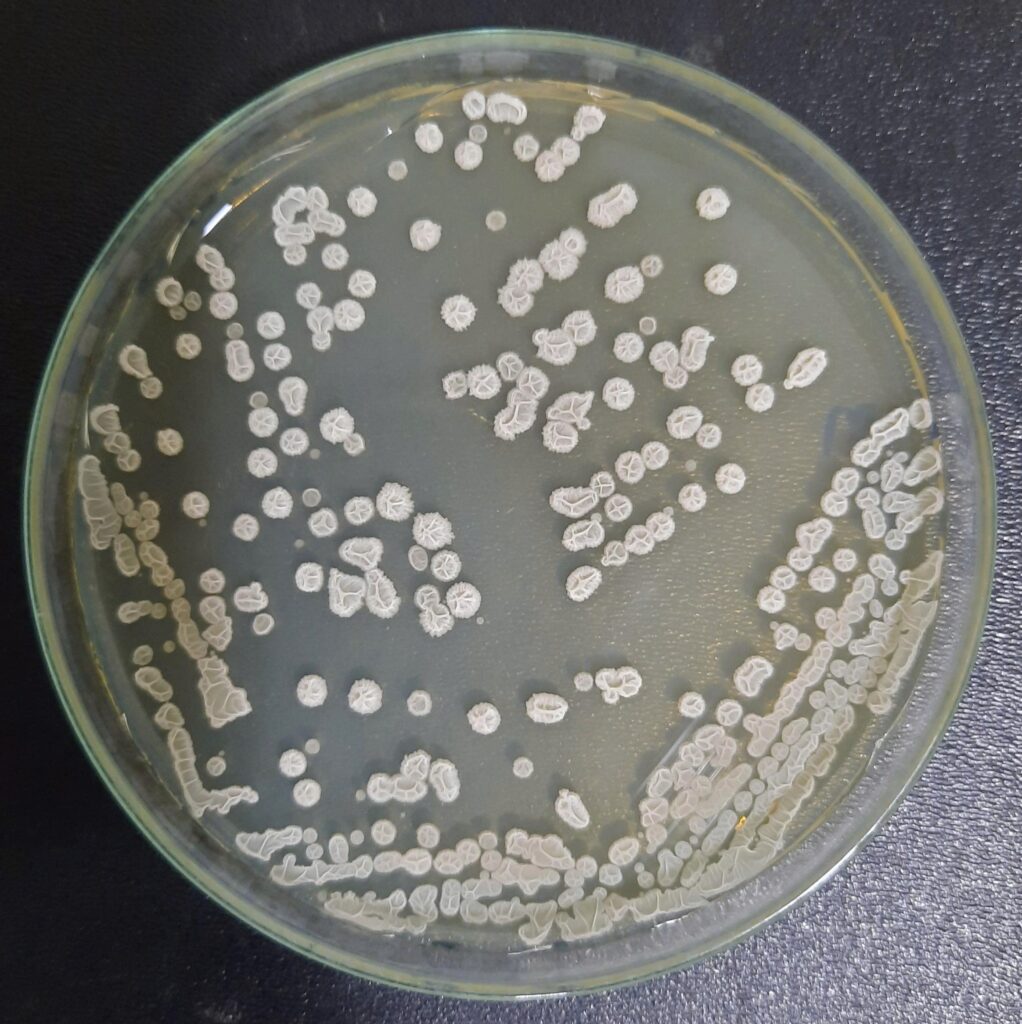
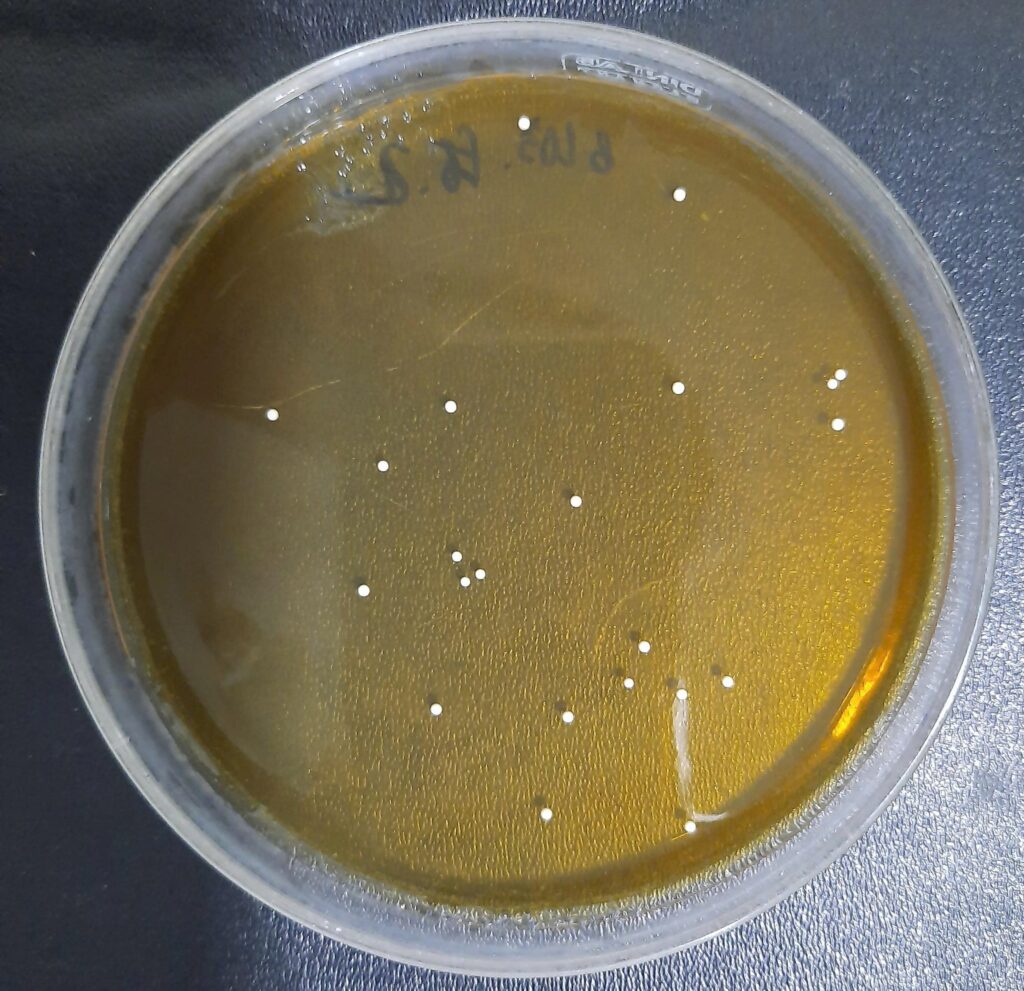
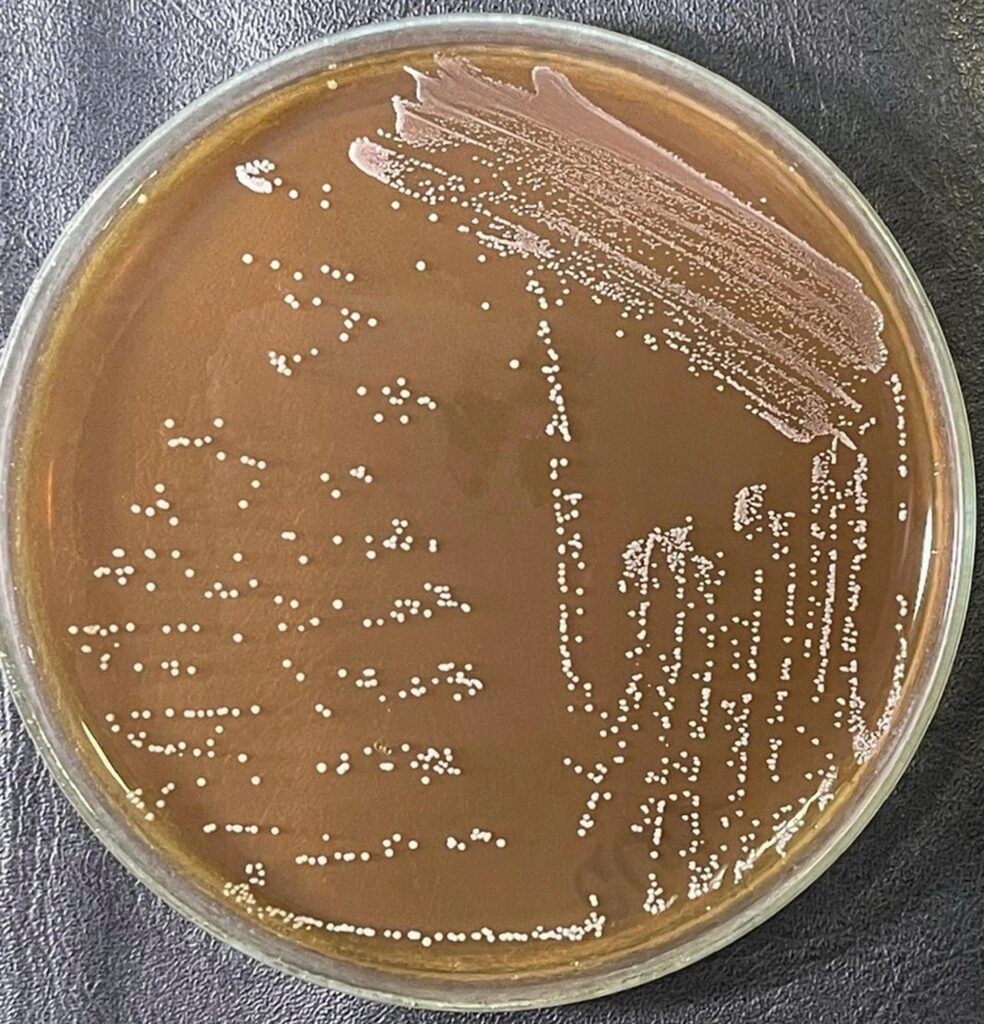
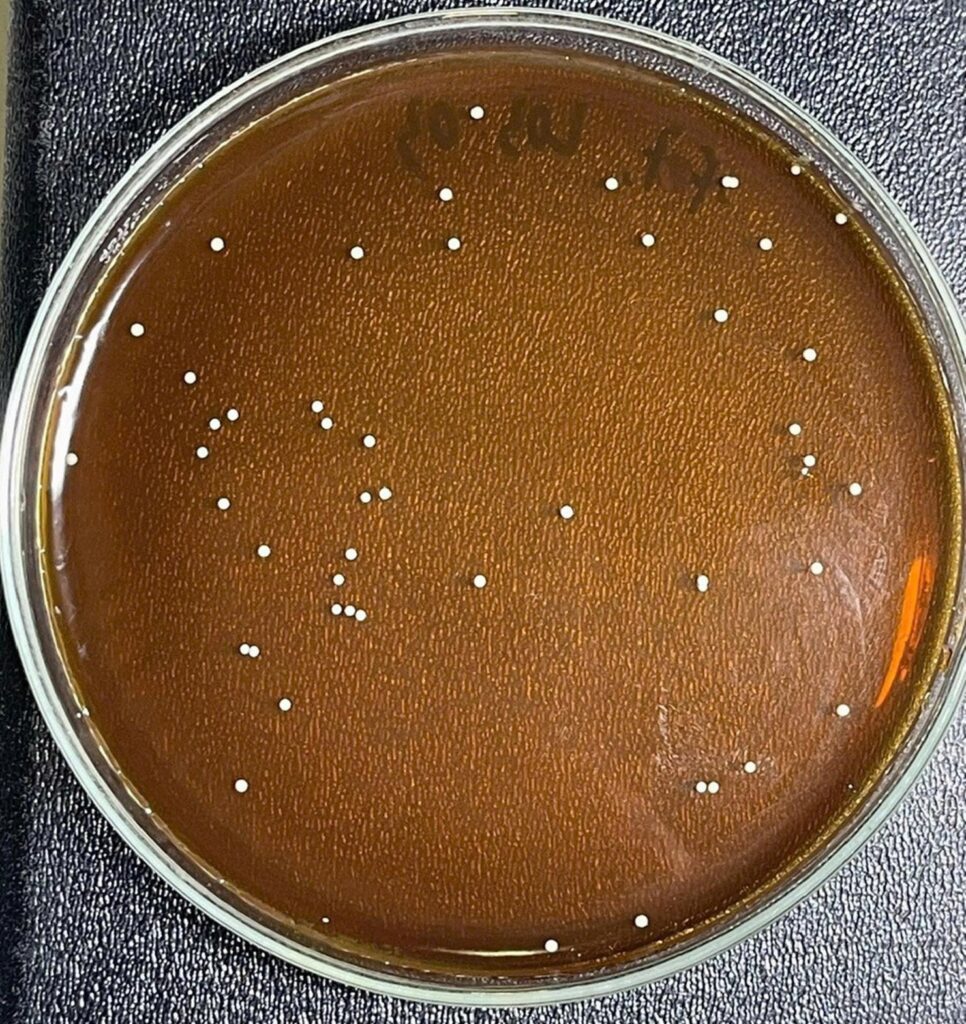
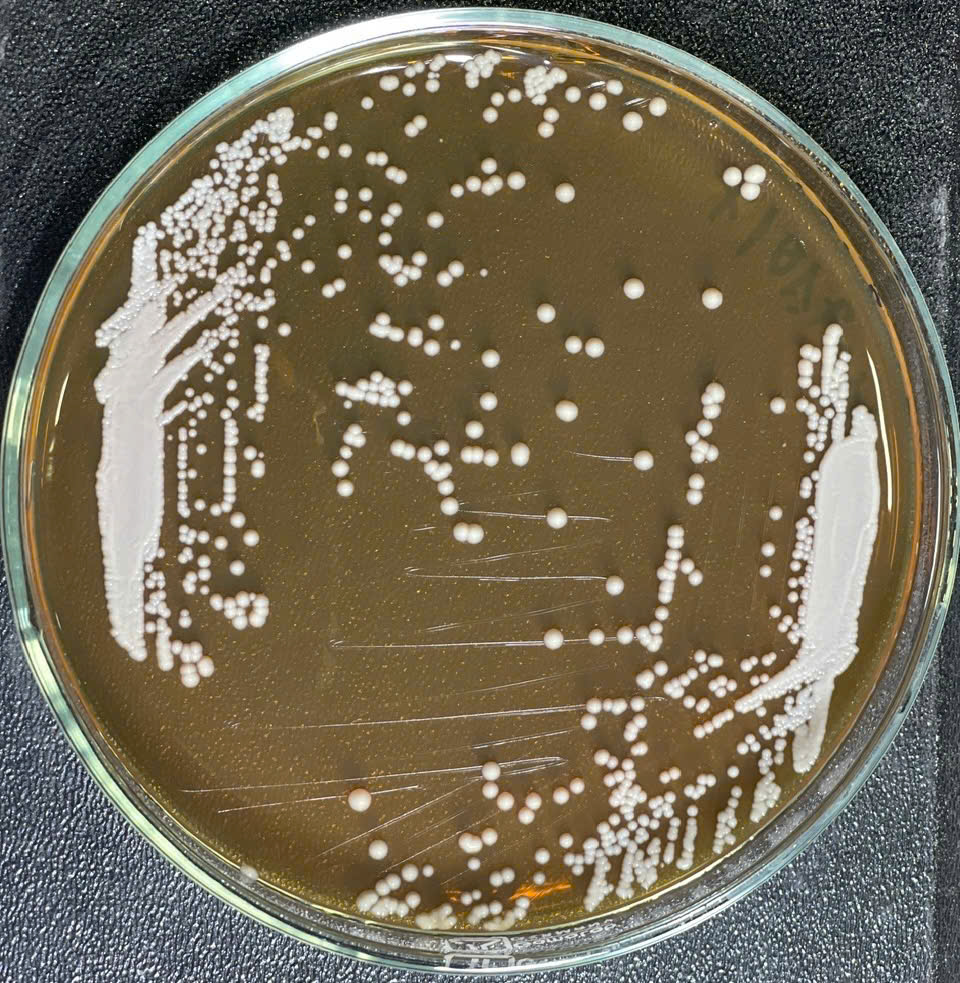
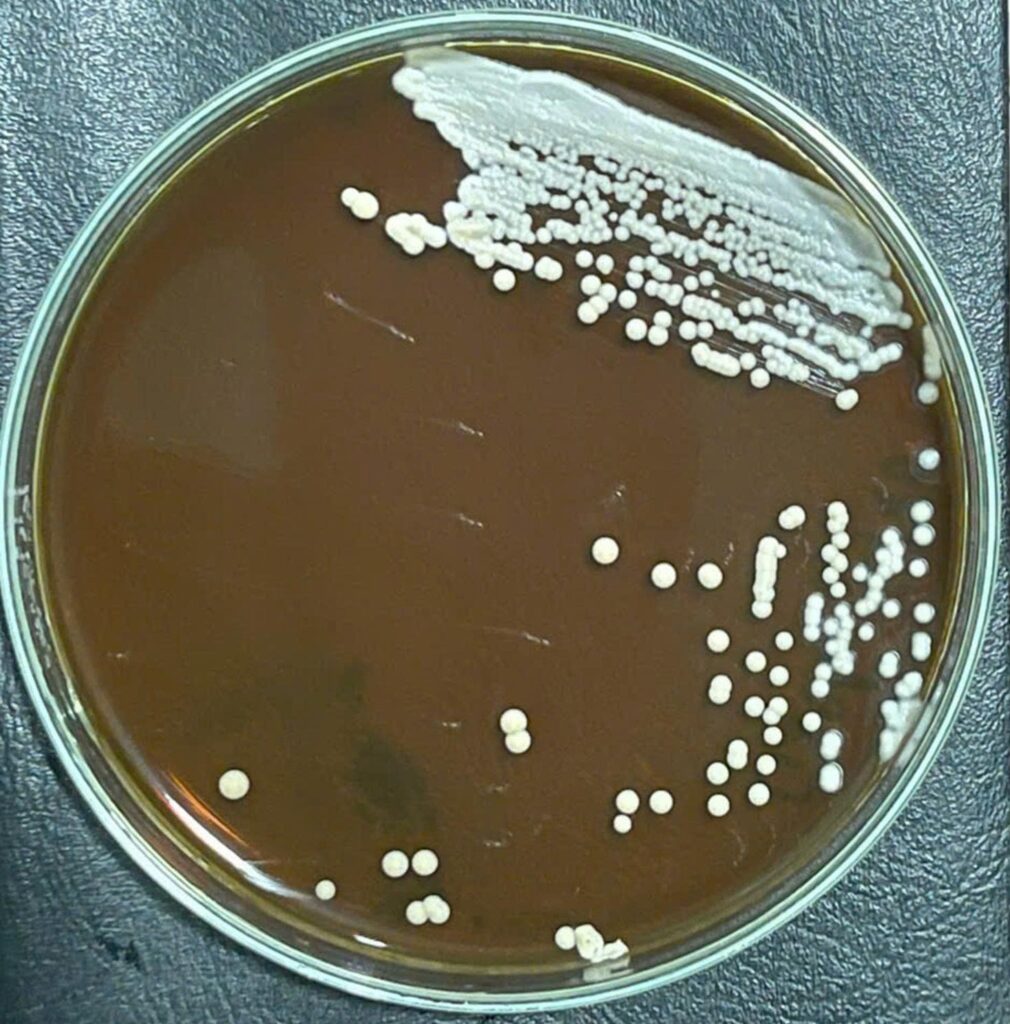
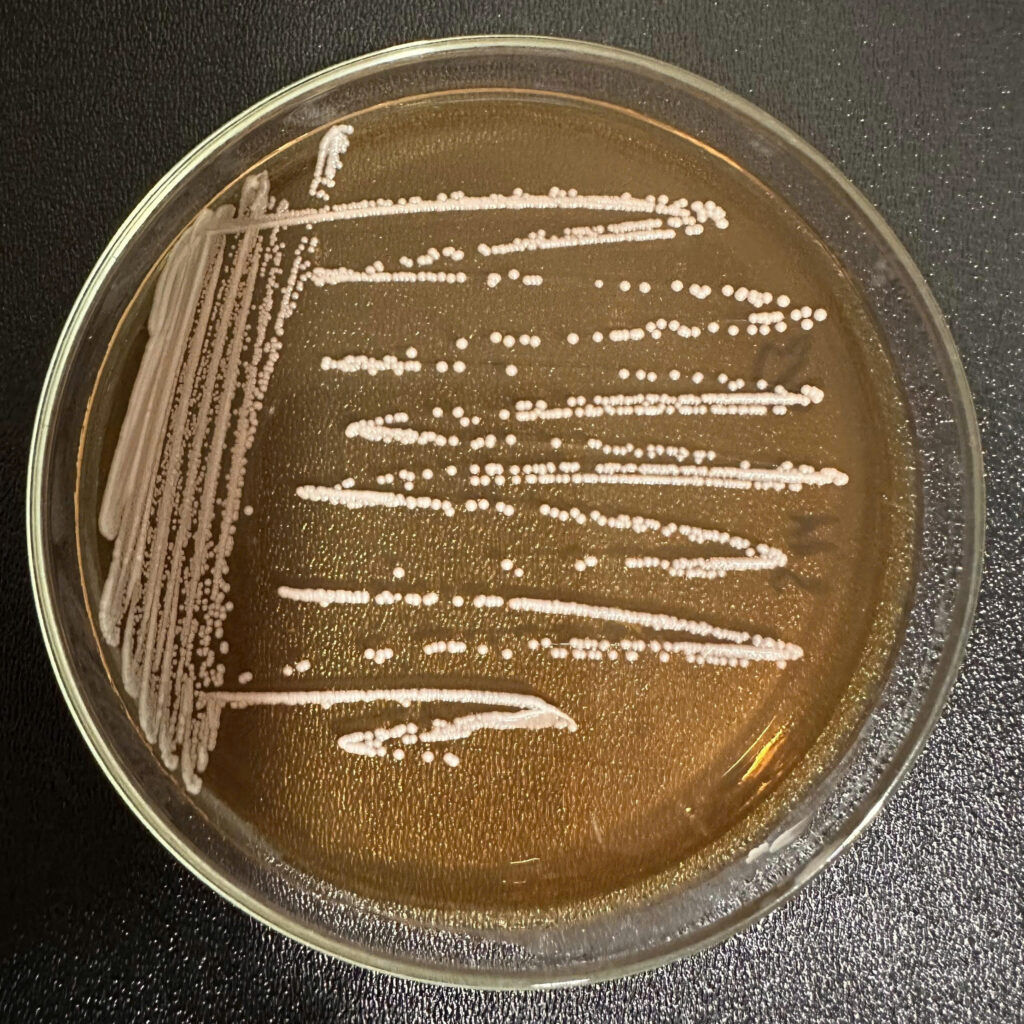
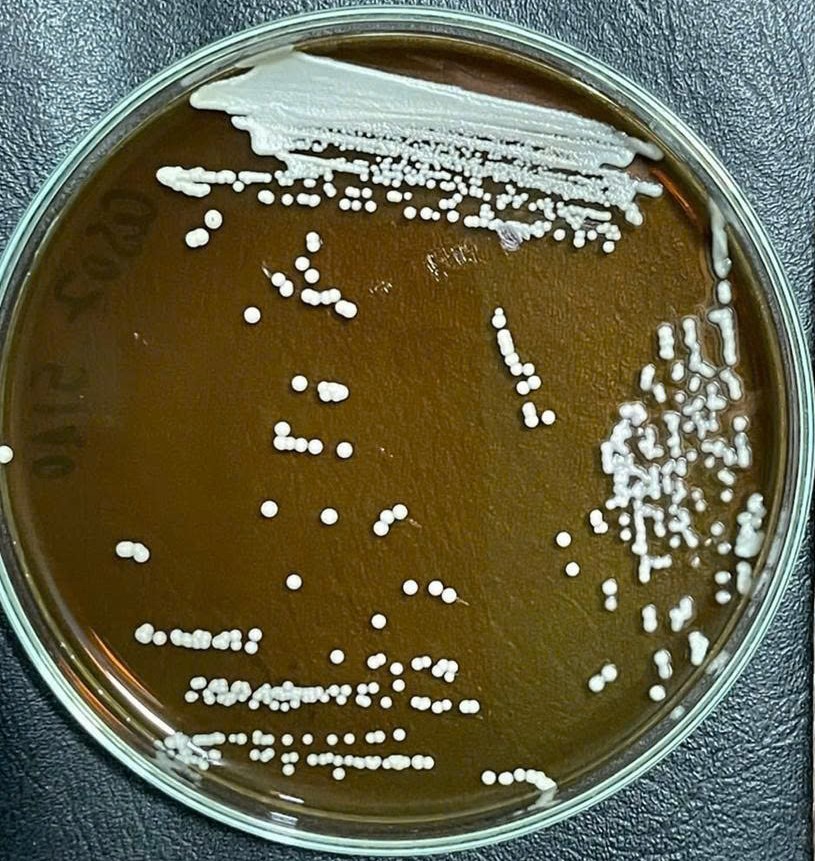
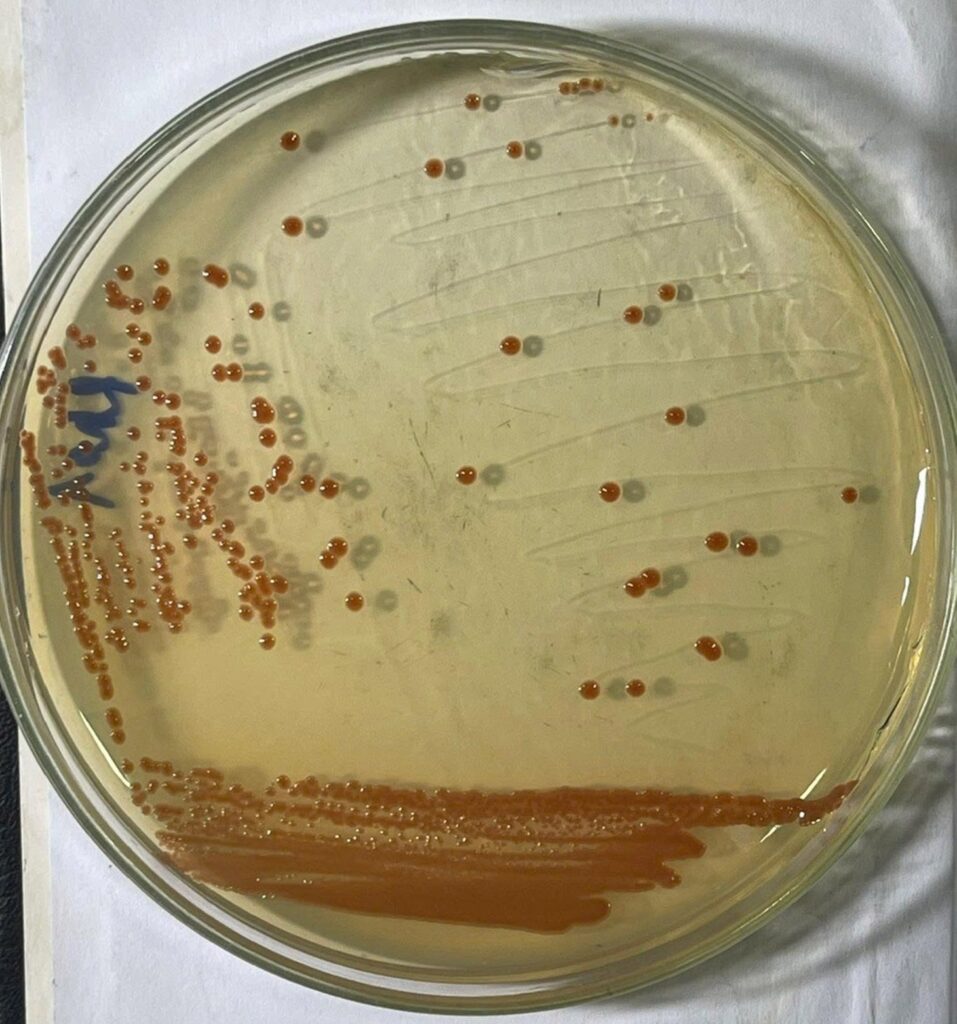

BIO-FLOC
Nơi bắt đầu những công thức vi sinh bản địa hiệu quả và bền vững
Chúng tôi không ngừng đầu tư vào phòng nghiên cứu với đội ngũ chuyên gia cùng quy trình kiểm nghiệm nghiêm ngặt nhằm tối ưu hiệu quả của ứng dụng vi sinh bản địa trong nuôi trồng thủy sản”.